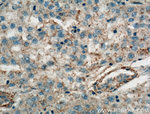
TMEM27 Antibody in Immunohistochemistry (Paraffin) (IHC (P))

Search
Proteintech
TMEM27 Polyclonal Antibody
{{$productOrderCtrl.translations['antibody.pdp.commerceCard.promotion.promotions']}}
{{$productOrderCtrl.translations['antibody.pdp.commerceCard.promotion.viewpromo']}}
{{$productOrderCtrl.translations['antibody.pdp.commerceCard.promotion.promocode']}}: {{promo.promoCode}} {{promo.promoTitle}} {{promo.promoDescription}}. {{$productOrderCtrl.translations['antibody.pdp.commerceCard.promotion.learnmore']}}
产品信息
19207-1-AP
种属反应
宿主/亚型
分类
类型
抗原
偶联物
形式
浓度
规格
纯化类型
保存液
内含物
保存条件
运输条件
产品详细信息
Immunogen sequence: VRLSIRTAL GDKAYAWDTN EEYLFKAMVA FSMRKVPNRE ATEISHVLLC NVTQRVSFWF VVTDPSKNHT LPAVEVQSAI RMNKNRINNA FFLNDQTLEF LKIPSTLAPP MDPSVPIW (27-143 aa encoded by BC050606 )
靶标信息
TMEM27 (Transmembrane protein 27) is also named as collectrin and Belongs to the TMEM27 family. It is a stimulator of beta cell replication and a membrane protein cleaved and shed by pancreatic beta cells that has been proposed as a beta cell mass biomarker. Western blot analysis of mouse collecting duct cell lines detected Tmem27 at an apparent molecular mass of 32 kDa. TMEM27 is an N-glycosylated protein and forms dimers, with MW of 64-75 kDa.
仅用于科研。不用于诊断过程。未经明确授权不得转售。
篇参考文献 (0)
生物信息学
蛋白别名: Collectrin; kidney-specific membrane protein; kidney-specific membrane protein NX-17; Transmembrane protein 27; unnamed protein product
基因别名: 0610008J07Rik; CLTRN; NX-17; NX17; TMEM27; UNQ679/PRO1312
UniProt ID: (Human) Q9HBJ8, (Mouse) Q9ESG4
Entrez Gene ID: (Human) 57393, (Mouse) 57394